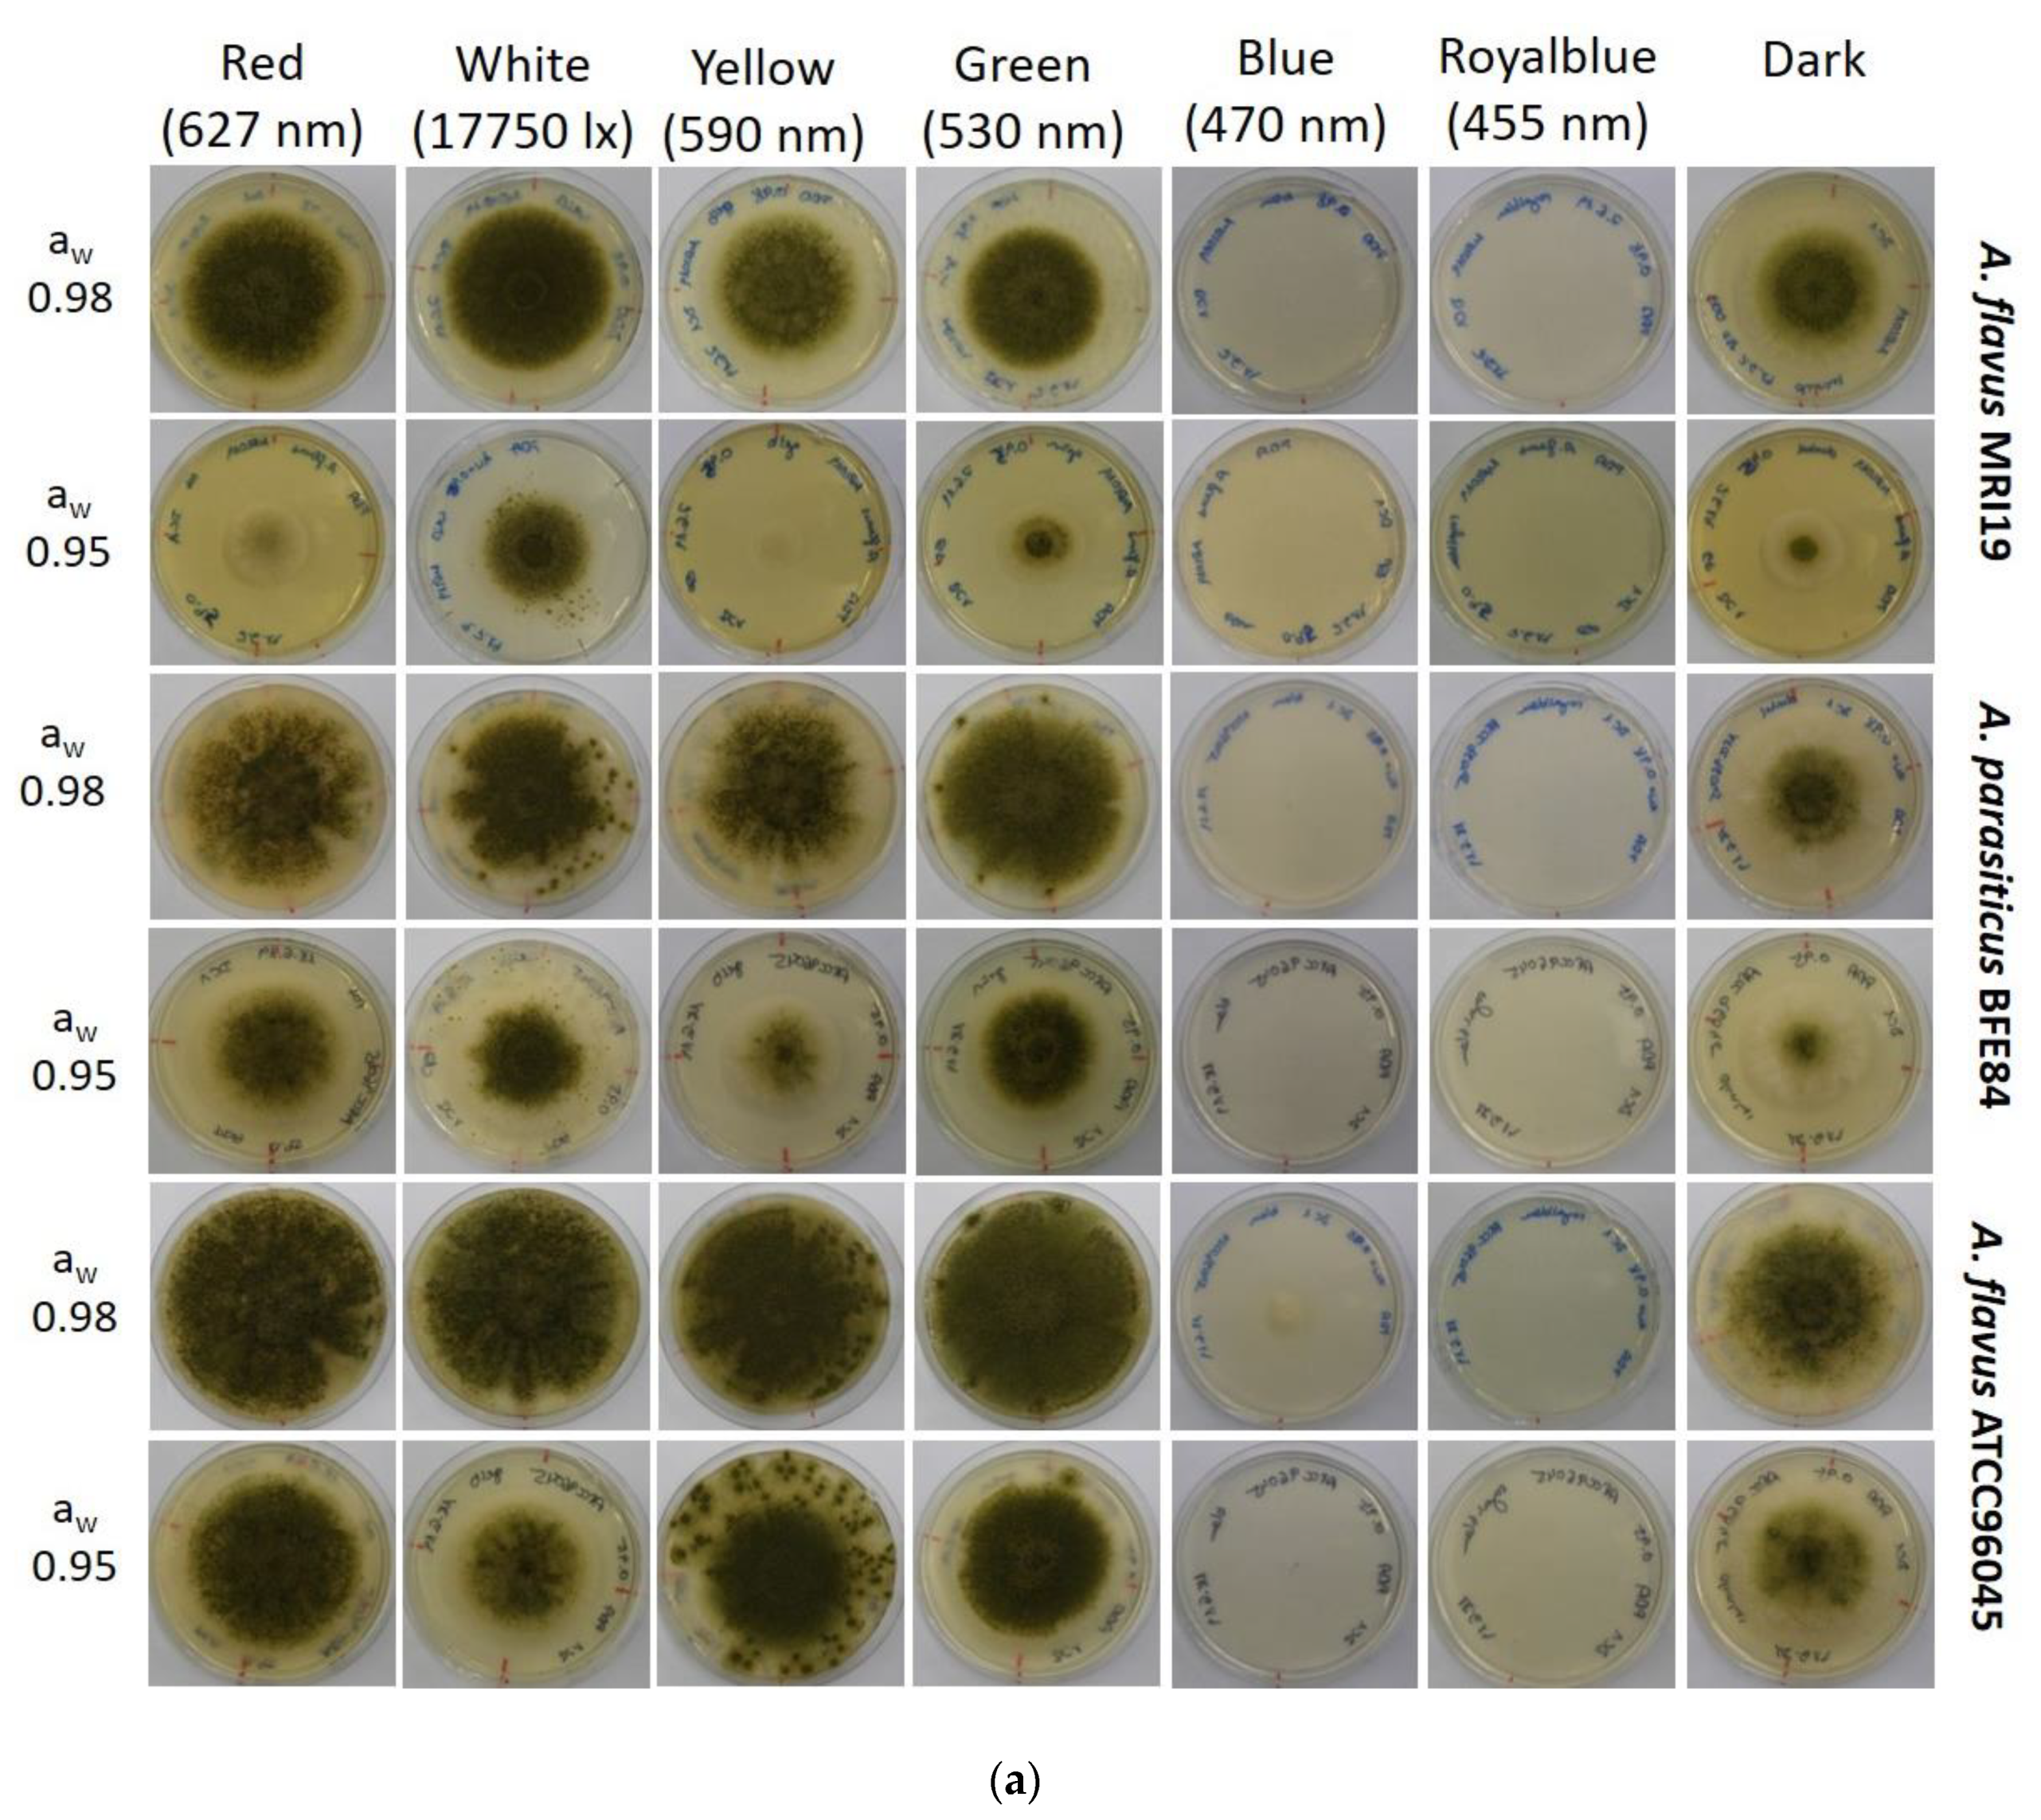
Microorganisms 08 02000 g001a Microorganisms 08 02000 g001a

Influence of Light and Water Activity on Growth and Mycotoxin Formation of Selected Isolates of Aspergillus flavus and Aspergillus parasiticus
Abstract
1. Introduction
2. Materials and Methods
2.1. Fungal Strains and Growth Conditions
2.2. Isolation of RNA, cDNA Synthesis and Real-Time PCR
2.3. Quantification of Aflatoxins and Cyclopiazonic Acid Using High-Performance Liquid Chromatography (HPLC)
2.4. Statistical Calculation
3. Results and Discussion
3.1. Growth of Aspergillus in Relation to Water Activity and Light
3.2. Aflatoxin Biosynthesis of Aspergillus in Relation to Water Activity and Light
3.3. Cyclopiazonic Acid (CPA) Biosynthesis of Aspergillus in Relation to Water Activity and Light
3.4. Transcriptional Activity of Mycotoxin Biosynthetic Genes in Aspergillus in Relation to Water Activity and Light
4. Conclusions
Author Contributions
Funding
Acknowledgments
Conflicts of Interest
References
- Eskola, M.; Kos, G.; Elliott, C.T.; Hajslova, J.; Mayar, S.; Krska, R. Worldwide contamination of food-crops with mycotoxins: Validity of the widely cited ‘FAO estimate’ of 25%. Crit. Rev. Food Sci. 2020, 60, 2773–2789. [Google Scholar] [CrossRef] [PubMed]
- Frisvad, J.C.; Hubka, V.; Ezekiel, C.N.; Hong, S.B.; Novakova, A.; Chen, A.J.; Arzanlou, M.; Larsen, T.O.; Sklenář, F.; Mahakarnchanakul, W.; et al. Taxonomy of Aspergillus section Flavi and their production of aflatoxins, ochratoxins and other mycotoxins. Stud. Mycol. 2019, 93, 1–63. [Google Scholar] [CrossRef] [PubMed]
- Koehler, P.E.; Hanlin, R.T.; Beraha, L. Production of Aflatoxins B1 and G1 by Aspergillus-Flavus and Aspergillus-Parasiticus Isolated from Market Pecans. Appl. Microbiol. 1975, 30, 581–583. [Google Scholar] [CrossRef] [PubMed]
- Baranyi, N.; Despot, D.J.; Palagyi, A.; Kiss, N.; Kocsube, S.; Szekeres, A.; Kecskeméti, A.; Bencsik, O.; Vágvölgyi, C.; Klarić, M.Š.; et al. Identification of Aspergillus Species in Central Europe Able to Produce G-Type Aflatoxins. Acta Biol. Hung. 2015, 66, 339–347. [Google Scholar] [CrossRef]
- Horn, B.; Dorner, J. Soil populations of Aspergillus species from section Flavi along a transect through peanut-growing regions of the United States. Mycologia 1998, 90, 767–776. [Google Scholar] [CrossRef]
- Arrus, K.; Blank, G.; Abramson, D.; Clear, R.; Holley, R. Aflatoxin production by Aspergillus flavus in Brazil nuts. J. Stored Prod. Res. 2005, 41, 513–527. [Google Scholar] [CrossRef]
- Benkerroum, N. Chronic and Acute Toxicities of Aflatoxins: Mechanisms of Action. Int. J. Environ. Res. Public Health 2020, 17, 423. [Google Scholar] [CrossRef]
- Battilani, P.; Toscano, P.; Van der Fels-Klerx, H.; Moretti, A.; Leggieri, M.C.; Brera, C.; Rortais, A.; Goumperis, T.; Robinson, T. Aflatoxin B 1 contamination in maize in Europe increases due to climate change. Sci. Rep. 2016, 6, 24328. [Google Scholar] [CrossRef]
- Klich, M.; Cary, J.; Beltz, S.; Bennett, C. Phylogenetic and morphological analysis of Aspergillus ochraceoroseus. Mycologia 2003, 95, 1252–1260. [Google Scholar] [CrossRef]
- Bennett, J.; Klich, M. Mycotoxins. Clin. Microbiol. Rev. 2003, 16, 497–516. [Google Scholar] [CrossRef]
- Atherstone, C.; Grace, D.; Lindahl, J.F.; Kang’ethe, E.K.; Nelson, F. Assessing the impact of aflatoxin consumption on animal health and productivity. Afr. J. Food Agric. Nutr. Dev. 2016, 16, 10949–10966. [Google Scholar] [CrossRef]
- Fink-Gremmels, J. Mycotoxins in cattle feeds and carry-over to dairy milk: A review. Food Addit. Contam. 2008, 25, 172–180. [Google Scholar] [CrossRef] [PubMed]
- Gong, Y.Y.; Turner, P.C.; Hall, A.J.; Wild, C.P. Aflatoxin exposure and impaired child growth in West Africa: An unexplored international public health burden. In Mycotoxins Detection Methods, Management, Public Health and Agricultural Trade; CABI: Wallingford, UK, 2008; pp. 53–66. ISBN 9781845930820. [Google Scholar]
- Meissonnier, G.M.; Pinton, P.; Laffitte, J.; Cossalter, A.-M.; Gong, Y.Y.; Wild, C.P.; Bertin, G.; Galtier, P.; Oswald, I.P. Immunotoxicity of aflatoxin B1: Impairment of the cell-mediated response to vaccine antigen and modulation of cytokine expression. Toxicol. Appl. Pharmacol. 2008, 231, 142–149. [Google Scholar] [CrossRef] [PubMed]
- Oswald, I.; Marin, D.; Bouhet, S.; Pinton, P.; Taranu, I.; Accensi, F. Immunotoxicological risk of mycotoxins for domestic animals. Food Addit. Contam. 2005, 22, 354–360. [Google Scholar] [CrossRef]
- Hove, M.; Van Poucke, C.; Njumbe-Ediage, E.; Nyanga, L.; De Saeger, S. Review on the natural co-occurrence of AFB1 and FB1 in maize and the combined toxicity of AFB1 and FB1. Food Control 2016, 59, 675–682. [Google Scholar] [CrossRef]
- Vaamonde, G.; Patriarca, A.; Pinto, V.F.; Comerio, R.; Degrossi, C. Variability of aflatoxin and cyclopiazonic acid production by Aspergillus section flavi from different substrates in Argentina. Int. J. Food Microbiol. 2003, 88, 79–84. [Google Scholar] [CrossRef]
- Luk, K.C.; Kobbe, B.; Townsend, J.M. Production of Cyclopiazonic Acid by Aspergillus-Flavus Link. Appl. Environ. Microb. 1977, 33, 211–212. [Google Scholar] [CrossRef]
- Holzapfel, C.W.; Schabort, J. Oxidative Cyclization of Beta-Cyclopiazonic Acid in Penicillium-Cyclopium Westling. S. Afr. J. Chem. 1977, 30, 233–235. [Google Scholar]
- Gallagher, R.T.; Richard, J.L.; Stahr, H.M.; Cole, R.J. Cyclopiazonic Acid Production by Aflatoxigenic and Non-Aflatoxigenic Strains of Aspergillus-Flavus. Mycopathologia 1978, 66, 31–36. [Google Scholar] [CrossRef]
- Purchase, I.F. Acute Toxicity of Mycotoxin Cyclopiazonic Acid to Rats. Toxicol. Appl. Pharmacol. 1971, 18, 114–123. [Google Scholar] [CrossRef]
- Seidler, N.W.; Jona, I.; Vegh, M.; Martonosi, A. Cyclopiazonic Acid Is a Specific Inhibitor of the Ca-2+-Atpase of Sarcoplasmic-Reticulum. J. Biol. Chem. 1989, 264, 17816–17823. [Google Scholar]
- Rangel, D.E.; Finlay, R.D.; Hallsworth, J.E.; Dadachova, E.; Gadd, G.M. Fungal strategies for dealing with environment-and agriculture-induced stresses. Fungal Biol. 2018, 122, 602–612. [Google Scholar] [CrossRef]
- Maggon, K.K.; Gupta, S.K.; Venkitasubramanian, T.A. Biosynthesis of aflatoxins. Bacteriol. Rev. 1977, 41, 822–855. [Google Scholar] [CrossRef]
- Yu, J.J.; Chang, P.K.; Ehrlich, K.C.; Cary, J.W.; Bhatnagar, D.; Cleveland, T.E.; Payne, G.A.; Linz, J.E.; Woloshuk, C.P.; Bennett, J.W. Clustered pathway genes in aflatoxin biosynthesis. Appl. Environ. Microb. 2004, 70, 1253–1262. [Google Scholar] [CrossRef] [PubMed]
- Caceres, I.; Al Khoury, A.; El Khoury, R.; Lorber, S.; Oswald, I.P.; Khoury, A.E.; Atoui, A.; Puel, O.; Bailly, J.D. Aflatoxin Biosynthesis and Genetic Regulation: A Review. Toxins 2020, 12, 150. [Google Scholar] [CrossRef] [PubMed]
- Schmidt-Heydt, M.; Geisen, R. A microarray for monitoring the production of mycotoxins in food. Int. J. Food Microbiol. 2007, 117, 131–140. [Google Scholar] [CrossRef] [PubMed]
- Baquiao, A.C.; Rodriges, A.G.; Lopes, E.L.; Tralamazza, S.M.; Zorzete, P.; Correa, B. Expression of Genes by Aflatoxigenic and Nonaflatoxigenic Strains of Aspergillus flavus Isolated from Brazil Nuts. Foodborne Pathog. Dis. 2016, 13, 434–440. [Google Scholar] [CrossRef]
- Schmidt-Heydt, M.; Magan, N.; Geisen, R. Stress induction of mycotoxin biosynthesis genes by abiotic factors. FEMS Microbiol. Lett. 2008, 284, 142–149. [Google Scholar] [CrossRef]
- Schmidt-Heydt, M.; Rufer, C.E.; Abdel-Hadi, A.; Magan, N.; Geisen, R. The production of aflatoxin B1 or G1 by Aspergillus parasiticus at various combinations of temperature and water activity is related to the ratio of aflS to aflR expression. Mycotoxin Res. 2010, 26, 241–246. [Google Scholar] [CrossRef]
- Medina, A.; Rodriguez, A.; Magan, N. Effect of climate change on Aspergillus flavus and aflatoxin B1 production. Front. Microbiol. 2014, 5, 348. [Google Scholar] [CrossRef]
- Schmidt-Heydt, M.; Abdel-Hadi, A.; Magan, N.; Geisen, R. Complex regulation of the aflatoxin biosynthesis gene cluster of Aspergillus flavus in relation to various combinations of water activity and temperature. Int. J. Food Microbiol. 2009, 135, 231–237. [Google Scholar] [CrossRef] [PubMed]
- Keller, N.P.; Nesbitt, C.; Sarr, B.; Phillips, T.D.; Burow, G.B. pH regulation of sterigmatocystin and aflatoxin biosynthesis in Aspergillus spp. Phytopathology 1997, 87, 643–648. [Google Scholar] [CrossRef] [PubMed]
- Crosthwaite, S.K.; Dunlap, J.C.; Loros, J.J. Neurospora wc-1 and wc-2: Transcription, photoresponses, and the origins of circadian rhythmicity. Science 1997, 276, 763–769. [Google Scholar] [CrossRef] [PubMed]
- Fanelli, F.; Schmidt-Heydt, M.; Haidukowski, M.; Geisen, R.; Logrieco, A.; Mulè, G. Influence of light on growth, fumonisin biosynthesis and FUM1 gene expression by Fusarium proliferatum. Int. J. Food Microbiol. 2012, 153, 148–153. [Google Scholar] [CrossRef] [PubMed]
- Fanelli, F.; Geisen, R.; Schmidt-Heydt, M.; Logrieco, A.; Mulè, G. Light regulation of mycotoxin biosynthesis: New perspectives for food safety. World Mycotoxin J. 2016, 9, 129–146. [Google Scholar] [CrossRef]
- Igbalajobi, O.; Yu, Z.; Fischer, R. Red-and Blue-Light Sensing in the Plant Pathogen Alternaria alternata Depends on Phytochrome and the White-Collar Protein LreA. mBio 2019, 10, e00371-19. [Google Scholar] [CrossRef]
- Schmidt-Heydt, M.; Rüfer, C.; Raupp, F.; Bruchmann, A.; Perrone, G.; Geisen, R. Influence of light on food relevant fungi with emphasis on ochratoxin producing species. Int. J. Food Microbiol. 2011, 145, 229–237. [Google Scholar] [CrossRef]
- Suzuki, T. Light-Irradiation Wavelength and Intensity Changes Influence Aflatoxin Synthesis in Fungi. Toxins 2018, 10, 31. [Google Scholar] [CrossRef]
- Aziz, N.; Moussa, L. Influence of white light, near-UV irradiation and other environmental conditions on production of aflatoxin B1 by Aspergillus flavus and ochratoxin A by Aspergillus ochraceus. Food Nahr. 1997, 41, 150–154. [Google Scholar] [CrossRef]
- Yu, Z.; Fischer, R. Light sensing and responses in fungi. Nat. Rev. Microbiol. 2019, 17, 25–36. [Google Scholar] [CrossRef]
- Stoll, D.; Schmidt-Heydt, M.; Geisen, R. Differences in the regulation of ochratoxin A by the HOG pathway in Penicillium and Aspergillus in response to high osmolar environments. Toxins 2013, 5, 1282–1298. [Google Scholar] [CrossRef] [PubMed]
- Schmidt-Heydt, M.; Stoll, D.A.; Mrohs, J.; Geisen, R. Intraspecific variability of HOG1 phosphorylation in Penicillium verrucosum reflects different adaptation levels to salt rich habitats. Int. J. Food Microbiol. 2013, 165, 246–250. [Google Scholar] [CrossRef] [PubMed]
- Graf, E.; Schmidt-Heydt, M.; Geisen, R. HOG MAP kinase regulation of alternariol biosynthesis in Alternaria alternata is important for substrate colonization. Int. J. Food Microbiol. 2012, 157, 353–359. [Google Scholar] [CrossRef]
- Liu, W.; Soulie, M.C.; Perrino, C.; Fillinger, S. The osmosensing signal transduction pathway from Botrytis cinerea regulates cell wall integrity and MAP kinase pathways control melanin biosynthesis with influence of light. Fungal Genet. Biol. 2011, 48, 377–387. [Google Scholar] [CrossRef] [PubMed]
- Magan, N.; Cayley, G.R.; Lacey, J. Effect of Water Activity and Temperature on Mycotoxin Production by Alternaria-Alternata in Culture and on Wheat-Grain. Appl. Environ. Microb. 1984, 47, 1113–1117. [Google Scholar] [CrossRef]
- Schmidt-Heydt, M.; Bode, H.; Raupp, F.; Geisen, R. Influence of light on ochratoxin biosynthesis by Penicillium. Mycotoxin Res. 2010, 26, 1–8. [Google Scholar] [CrossRef] [PubMed]
- Gibson, A.M.; Baranyi, J.; Pitt, J.I.; Eyles, M.J.; Roberts, T.A. Predicting fungal growth: The effect of water activity on Aspergillus flavus and related species. Int. J. Food Microbiol. 1994, 23, 419–431. [Google Scholar] [CrossRef]
- Sandven, P. Does the mycotoxin citrinin function as a sun protectant in conidia from Penicillium verrucosum. Mycopathologia 1998, 142, 43–47. [Google Scholar]
- Schmidt-Heydt, M.; Stoll, D.; Schütz, P.; Geisen, R. Oxidative stress induces the biosynthesis of citrinin by Penicillium verrucosum at the expense of ochratoxin. Int. J. Food Microbiol. 2015, 192, 1–6. [Google Scholar] [CrossRef]
- Bennett, J.; Fernholz, F.; Lee, L. Effect of light on aflatoxins, anthraquinones, and sclerotia in Aspergillus flavus and A. parasiticus. Mycologia 1978, 70, 104–116. [Google Scholar] [CrossRef]
- Joffe, A.; Lisker, N. Effects of light, temperature, and pH value on aflatoxin production in vitro. Appl. Environ. Microbiol. 1969, 18, 517–518. [Google Scholar] [CrossRef]
- Plotnikov, V.K.; Bakaldina, N.B.; Novikov, B.N.; Alekseenko, Z.V.; Bibishev, V.; Polezhaev, S.L.; Riadchikov, V.G. Post-transcriptional regulation of gene expression in eukaryotes: Effect of stressors on mRNA stability in vitro. Genetika 1998, 34, 1205–1211. [Google Scholar]
- Liebhaber, S.A. mRNA stability and the control of gene expression. Nucleic Acids Symp. Ser. 1997, 36, 29–32. [Google Scholar]
- Abdel-Hadi, A.; Schmidt-Heydt, M.; Parra, R.; Geisen, R.; Magan, N. A systems approach to model the relationship between aflatoxin gene cluster expression, environmental factors, growth and toxin production by Aspergillus flavus. J. R. Soc. Interface 2012, 9, 757–767. [Google Scholar] [CrossRef] [PubMed]
- Bayram, O.; Feussner, K.; Dumkow, M.; Herrfurth, C.; Feussner, I.; Braus, G.H. Changes of global gene expression and secondary metabolite accumulation during light-dependent Aspergillus nidulans development. Fungal Genet. Biol. 2016, 87, 30–53. [Google Scholar] [CrossRef]
- Fanelli, F.; Schmidt-Heydt, M.; Haidukowski, M.; Geisen, R.; Logrieco, A.; Mulé, G. Influence of light on growth, conidiation and the mutual regulation of fumonisin B2 and ochratoxin A biosynthesis by Aspergillus niger. World Mycotoxin J. 2012, 5, 169–176. [Google Scholar] [CrossRef]
- Jayashree, T.; Subramanyam, C. Oxidative stress as a prerequisite for aflatoxin production by Aspergillus parasiticus. Free Radic. Biol. Med. 2000, 29, 981–985. [Google Scholar] [CrossRef]
- Sies, H. Hydrogen peroxide as a central redox signaling molecule in physiological oxidative stress: Oxidative eustress. Redox Biol. 2017, 11, 613–619. [Google Scholar] [CrossRef] [PubMed]
- Santosa, S.; Jones, P.J.H. Ophthalmology-Oxidative stress in ocular disease: Does lutein play a protective role? Can. Med. Assoc. J. 2005, 173, 861–862. [Google Scholar] [CrossRef] [PubMed]
- Narasaiah, K.V.; Sashidhar, R.B.; Subramanyam, C. Biochemical analysis of oxidative stress in the production of aflatoxin and its precursor intermediates. Mycopathologia 2006, 162, 179–189. [Google Scholar] [CrossRef] [PubMed]
- Boettger, D.; Hertweck, C. Molecular diversity sculpted by fungal PKS–NRPS hybrids. ChemBioChem 2013, 14, 28–42. [Google Scholar] [CrossRef] [PubMed]
- Miraglia, M.; Marvin, H.; Kleter, G.; Battilani, P.; Brera, C.; Coni, E.; Cubadda, F.; Croci, L.; De Santis, B.; Dekkers, S.; et al. Climate change and food safety: An emerging issue with special focus on Europe. Food Chem. Toxicol. 2009, 47, 1009–1021. [Google Scholar] [CrossRef] [PubMed]

Publisher’s Note: MDPI stays neutral with regard to jurisdictional claims in published maps and institutional affiliations. |
© 2020 by the authors. Licensee MDPI, Basel, Switzerland. This article is an open access article distributed under the terms and conditions of the Creative Commons Attribution (CC BY) license (http://creativecommons.org/licenses/by/4.0/).
Share and Cite
Priesterjahn, E.-M.; Geisen, R.; Schmidt-Heydt, M. Influence of Light and Water Activity on Growth and Mycotoxin Formation of Selected Isolates of Aspergillus flavus and Aspergillus parasiticus. Microorganisms 2020, 8, 2000. https://doi.org/10.3390/microorganisms8122000
Priesterjahn E-M, Geisen R, Schmidt-Heydt M. Influence of Light and Water Activity on Growth and Mycotoxin Formation of Selected Isolates of Aspergillus flavus and Aspergillus parasiticus. Microorganisms. 2020; 8(12):2000. https://doi.org/10.3390/microorganisms8122000
Chicago/Turabian StylePriesterjahn, Eva-Maria, Rolf Geisen, and Markus Schmidt-Heydt. 2020. "Influence of Light and Water Activity on Growth and Mycotoxin Formation of Selected Isolates of Aspergillus flavus and Aspergillus parasiticus" Microorganisms 8, no. 12: 2000. https://doi.org/10.3390/microorganisms8122000
APA StylePriesterjahn, E.-M., Geisen, R., & Schmidt-Heydt, M. (2020). Influence of Light and Water Activity on Growth and Mycotoxin Formation of Selected Isolates of Aspergillus flavus and Aspergillus parasiticus. Microorganisms, 8(12), 2000. https://doi.org/10.3390/microorganisms8122000

